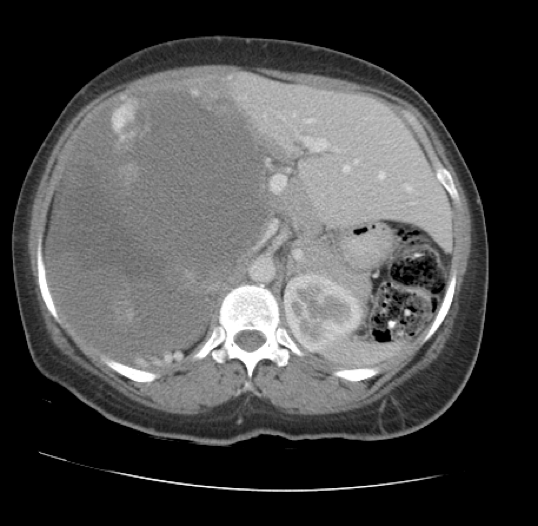
Fig 2

Peer Reviewed
Giant Hepatic Hemangioma
Authors:
Drew Leggett, BS, PA-S
Barry University, Miami Shores, Florida
Madhuri Duggirala, BS, MS-III
Nova Southeastern University, Fort Lauderdale, Florida
Syed A. A. Rizvi, PhD, MS, MBA
Hampton University School of Pharmacy, Hampton, Virginia
Zafar Qureshi, MD
UHI CommunityCare Clinic, Miami, Florida
Jacquelline Leva, DO
Westchester General Hospital, Miami, Florida
Syed S. Hussain, BS
Florida International University, Miami, Florida
Citation:
Leggett D, Duggirala M, Rizvi SAA, Qureshi Z, Leva J, Hussain SS. Giant hepatic hemangioma. Consultant. 2019;59(6):178-179, 192.
A 58-year-old woman presented with a giant hepatic hemangioma, seeking clearance to start a full-time custodial position. Approximately 6 years prior, the patient had been given a diagnosis of a benign liver growth, which had been detected via ultrasonography and abdominal computed tomography (CT) scans. She had not experienced any symptoms such as pain or abdominal discomfort at that time. However, a history of pancytopenia and enlarged axillary lymph nodes, likely related to the patient’s hepatic pathology, had been noted. Additionally, the patient had a history of thyroid enlargement. She denied any substance abuse or alcohol consumption.
Physical examination. The patient appeared well developed and in no apparent distress. Her height was 165.1 cm and her weight was 78.5 kg, with a body mass index of 28.8 kg/m2. Her blood pressure was 133/76 mm Hg, oxygen saturation was 98%, pulse was 81 beats/min, respiratory rate was 17 breaths/min, and temperature 36.6°C.
Examination of the abdomen revealed obvious right-sided enlargement. The mass was lightly palpated and noted to extend from the right lobe of the liver to the level of the navel. The patient reported no pain or tenderness. No bruits were auscultated. Palpation of the axillary lymph nodes was performed based on the patient’s history, but no enlarged lymph nodes were noted.
Diagnostic tests. Approximately 4 years ago, ultrasonography had exposed a heterogeneous hypoechoic lesion along the right lobe of the liver measuring 12 × 10 × 11 cm (Figure 1).

Figure 1. Ultrasonogram showing a mass in the right lobe of the liver.
Later that year, CT of the abdomen and pelvis with intravenous (IV) contrast showed a large heterogeneous peripherally and nodular enhancing mass (17.4 × 13.7 × 16.8 cm) occupying most of the right hepatic lobe, causing hepatic enlargement and mass effect on the adjacent abdominal viscera (Figure 2).
Figure 2. Transverse CT scan showing a mass occupying most of the right lobe of the liver.
A magnetic resonance imaging (MRI) scan of the abdomen 2 years ago without IV contrast had revealed a large multilocular and septate mixed-intensity liver lesion involving essentially all of the right lobe, measuring 26 × 18 × 16 cm (Figure 3). MRI with IV contrast indicated a progressive peripheral pattern of nodular enhancement, which was strongly suggestive of a giant hepatic hemangioma. No splenomegaly was present.

Figure 3. T2-weighted MRI scan showing a lesion involving essentially all of the right lobe of the liver.
More recently, ultrasonography had shown no further growth of the giant hemangioma and a spleen length of 8.9 cm. Results of a complete blood cell count were as follows: white blood cell count, 2700/µL; absolute neutrophil count, 1092/µL; hemoglobin, 10.0 g/dL; hematocrit, 31.2%; and platelet count, 122 × 103/μL. These findings were considered in the report to represent stable pancytopenia.
Discussion. Hepatic hemangiomas are benign mesenchymal hepatic growths that often present as solitary lesions and are usually located in the right lobe.1-3 Depending on the size, they are characterized as capillary hemangiomas (<3 cm), medium hemangiomas (between 3 and 10 cm) and giant or cavernous hemangiomas (>10 cm),4,5 the latter of which was the case with our patient.
In most instances, the lesion is asymptomatic and is discovered incidentally.6 Patients typically experience symptoms with larger masses, specifically those measuring greater than 4 cm.6 Common symptoms include abdominal pain secondary to thrombosis or bleeding in the tumor.2 The lesion is usually diagnosed in patients between 30 and 50 years of age and occurs more often in women.7
The growth of hepatic hemangioma with time is not well understood. However, larger masses seem to show more growth than smaller tumors.8 Spontaneous rupture of hepatic hemangiomas, including giant hemangiomas, is rare.9 However, rupture tends to occur more often in peripherally located hemangiomas.10
MRI is typically used to diagnose giant hepatic hemangiomas. Giant hemangiomas can show heterogeneity centrally if thrombosis or fibrosis is present and hyperintensity on T2-weighted MRI with globular enhancement peripherally.
If the results of imaging studies demonstrate the classic findings pathognomonic of hepatic hemangiomas, follow-up imaging is not recommended. Moreover, conservative treatment is appropriate for patients who are asymptomatic.11,12
On the other hand, if the patient has symptoms, and other potential etiologies of the symptoms have been ruled out, surgical resection may be performed, because compression of nearby structures may be the cause. Surgical resection is performed very rarely, in approximately 2% of cases.3 The indications for surgery include rupture and intraperitoneal bleeding, incapacitating symptoms, and cases in which malignancy is not able to be ruled out with other imaging studies.13 Upon surgical resection, hepatic hemangiomas—even giant hemangiomas—are rarely found to be malignant vascular tumors.3 The 4 surgical procedures for hepatic hemangiomas are liver resection, enucleation, hepatic artery ligation, and liver transplantation. The method that is used is based on the individual patient, given that no one procedure is superior to another in terms of morbidity, mortality, and transfusion requirement.14 Arterial embolization is a nonsurgical procedure that manages acute bleeding and shrinks the hemangiomas prior to surgery.13
Outcome of the case. Our patient has had repeated imaging studies to monitor her giant hepatic hemangioma since its discovery. As noted, surgical treatment is indicated if rapid growth is noted, if the risk of rupture is high, and if malignancy is suspected,15 none of which are the case in our patient. Despite her history of stable pancytopenia, presumably related to the giant hepatic hemangioma, pancytopenia is only an indication for surgery if it is life-threatening. Whether the patient and the surgical team would opt for this treatment in the future would depend on a number of factors, including worsening pancytopenia, age-related risk, adjacent relationship of the hemangioma to the hepatic vena cava,16 and the patient’s desire to undergo surgery. Currently, the patient only has mild discomfort; she will continue to be monitored and evaluated for the status of the tumor and her overall health.
- Tait N, Richardson AJ, Muguti G, Little JM. Hepatic cavernous haemangioma: a 10 year review. Aust N Z J Surg. 1992;62(7):521-524.
- John TG, Greig JD, Crosbie JL, Miles WF, Garden OJ. Superior staging of liver tumors with laparoscopy and laparoscopic ultrasound. Ann Surg. 1994;220(6):711-719.
- Baer HU, Dennison AR, Mouton W, Stain SC, Zimmermann A, Blumgart LH. Enucleation of giant hemangiomas of the liver. Technical and pathologic aspects of a neglected procedure. Ann Surg. 1992;216(6):673-676.
- Bajenaru N, Balaban V, Săvulescu F, Campeanu I, Patrascu T. Hepatic hemangioma -review-. J Med Life. 2015;8:4-11.
- Zhang W, Huang Z-Y, Ke C-S, et al. Surgical treatment of giant liver hemangioma larger than 10 cm: a single center’s experience with 86 patients. Medicine (Baltimore). 2015;94(34):e1420.
- Goodman ZD. Benign tumors of the liver. In: Okuda K, Ishak KG, eds. Neoplasms of the Liver. Tokyo, Japan: Springer; 1987:105-125.
- Gandolfi L, Leo P, Solmi L, Vitelli E, Verros G, Colecchia A. Natural history of hepatic haemangiomas: clinical and ultrasound study. Gut. 1991;32(6):677-180.
- Hasan HY, Hinshaw JL, Borman EJ, Gegios A, Leverson G, Winslow ER. Assessing normal growth of hepatic hemangiomas during long-term follow-up. JAMA Surg. 2014; 149(12):1266-1271.
- Gilon D, Slater PE, Benbassat J. Can decision analysis help in the management of giant hemangioma of the liver? J Clin Gastroenterol. 1991;13(3):255-258.
- Pietrabissa A, Giulianotti P, Campatelli A, et al. Management and follow-up of 78 giant haemangiomas of the liver. Br J Surg. 1996;83(7):915-918.
- European Association for the Study of the Liver (EASL). EASL clinical practice guidelines on the management of benign liver tumours. J Hepatol. 2016;65(2):386-398.
- Choi BY, Nguyen MH. The diagnosis and management of benign hepatic tumors. J Clin Gastroenterol. 2005;39(5):401-4
- Farges O, Daradkeh S, Bismuth H. Cavernous hemangiomas of the liver: are there any indications for resection? World J Surg. 1995;19(1):19-24.
- Giuliante F, Ardito F, Vellone M, et al. Reappraisal of surgical indications and approach for liver hemangioma: single-center experience on 74 patients. Am J Surg. 2011;201(6):741-748.
- Liu Y, Wei X, Wang K, et al. Enucleation versus anatomic resection for giant hepatic hemangioma: a meta-analysis. Gastrointest Tumors. 2017;3(3-4):153-162.
- Akamatsu N, Sugawara Y, Komagome M, et al. Giant liver hemangioma resected by trisectorectomy after efficient volume reduction by transcatheter arterial embolization: a case report. J Med Case Rep. 2010;4:283.
